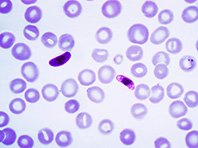

Медицинские центры Университета Радбоуд и Лейденского университета, передает Medical Express, протестировали экспериментальную вакцину против малярии, в основе которой лежит генетически ослабленный малярийный паразит Plasmodium falciparum. Было доказано, что вакцина безопасна и вызывает иммунный ответ.
Малярийный паразит Plasmodium falciparum был ослаблен за счет удаления двух генов. Напомним: паразит передается с укусом москита. Оказавшись в теле человека, паразит развивается в печени в течение примерно семи дней. Далее он трансформируется и переходит из печени в кровь, где может поразить эритроциты. Благодаря проведенным манипуляциям паразит достигает первой, печеночной стадии развития, но не переходит на более поздние стадии и не вызывает заражение крови.
В рамках испытаний 67 добровольцам делали инъекции вакцины, изготовленной из генетически модифицированного паразита (названного PfSPZ GA1). Это, подчеркивают ученые, первая в мире инъекционная, генетически ослабленная вакцина против малярии. Тестировались две дозы - большая и малая. В обоих случаях вакцина показала свою безопасность, способность предотвращать заражение крови и появление симптомов малярии. Правда, иммунная защита от малярийной инфекции не была полной. То есть вакцина требует доработки.

1
2
3
Комментарии (0)